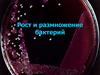
Рост и размножение бактерий

Похожие презентации:
Способы размножения прокариот
1. СПОСОБЫ РАЗМНОЖЕНИЯ ПРОКАРИОТ
2.
Бактерии размножаются бесполым путем(возможен лишь частичный обмен участками
генома).
Особенности прокариот
Высокие темпы
размножения в
благоприятных условиях
(взрывной тип
размножения).
Способность долгое время
обходиться без
размножения в
неблагоприятных
условиях - находятся в
стадии покоя (цисты,
споры).
3.
Способы размножения прокариотБинарное
деление (у
большинства).
Почкование
Множественное
деление
4.
Бинарное деление – равновеликое поперечное делениеклетки, с образованием двух равноценных дочерних клеток без
предварительного обмена генетической информацией (амитоз);
включает:
1) Фаза роста: увеличение РНК →
белка → ДНК, массы и размера клетки.
2) Репликация хромосомной ДНК (по
полуконсервативному механизму).
3) Фаза цитокинеза - деление клетки:
у грам(+) бактерий (А) путем формирования
перегородки, у грам(-) бактерий (Б) –
перетяжки.
4) Фаза расхождения дочерних особей
- клетки расходятся или формируют агрегаты
(цепочки клеток, тетрады, пакеты и т.д.).
1 - клеточная стенка
материнской клетки
(толстая линия), заново
синтезированная (тонкая
линия); 2 - ЦПМ; 3 –
мембр. структура; 4 –
цитоплазма с нуклеоидом.
5.
ПочкованиеМножественное
деление
Встречаются редко у прокариот
(напр., у фототрофов р. Rhodomicrobium)
(у одноклеточных цианобактерий)
На одном из полюсов материнской
клетки образуется вырост (почка), он
увеличивается и достигает ее
размеров.
Репликации бактериальной
хромосомы
Вегетативная клетка увеличивается и
претерпевает ряд быстрых
последовательных бинарных делений.
Образующиеся клетки не растут, а сразу
приступают к делению. Образуется от 4
до 1000 мелких клеток – баеоцистов.
Репликация бактериальной
хромосомы
Отделение почки от
материнской клетки
3
1 - клеточная стенка (КС);
2 - ЦПМ;
3 – дополнит.
фибриллярный слой КС.
1
2
6. РОСТ МИКРООРГАНИЗМОВ
7. Вопросы:
1. Параметры микробного роста.2. Рост бактерий в периодической
культуре.
3. Рост бактерий в непрерывной
культуре.
8.
• В микробиологии есть два понятия:рост клеток
рост популяции м-о.
• Рост популяции м-о – увеличение
числа особей в локальной популяции
м-о, вызванное их размножением.
9. 1. Параметры микробного роста
• Многие одноклеточные м-оразмножаются делением пополам и
их число в оптимальных условиях
растет в геометрической
прогрессии: 20 → 21 → 22 → … 2n.
10.
• Численность клеток в момент времени t:Nt = N0 · 2n,
где N0 - исходное кол-во клеток; Nt – кол-во
клеток в момент времени t; n – число
делений за время t (24, 48 часов и т.д.).
• Логарифмируя, получим:
lg Nt = lg N0 · n lg 2
11.
• n – число клеточных делений завремя t:
12.
• Число клеточных делений (V) заединицу времени (за час) (V константа скорости деления):
13.
• Время, требующееся для одногоцикла делений, или время генерации
– g (время удвоения численности
популяции):
14.
• Скорость прироста клеток пропорциональнаначальной их концентрации.
• Коэффициент пропорциональности (μ) –
удельная скорость роста.
• μ – прирост числа клеток (биомассы) за единицу
времени, например, за час (час-1).
• μ различна для разных культур; может меняться
в зависимости от условий выращивания.
15.
• При сбалансированном росте(сбалансированный рост –
пропорционально числу клеток
увеличивается их масса) удельная
скорость роста μ:
16. 2. Рост бактерий в периодической культуре
• Периодическая культура (ПК) - закрытаясистема.
• В ПК развитие культуры идет в фиксированном
объеме среды, условия все время меняются,
численность клеток возрастает, а концентрация
субстрата уменьшается.
• По мере истощения питательных ресурсов и
накопления продуктов обмена до токсичной
концентрации рост прекращается.
17.
Рост в периодической культуре:1. лаг-фаза; 2. экспоненциальная фаза; 3. стационарная фаза;
4. фаза отмирания.
18.
• Лаг-фаза – фаза физиологическогоприспособления; идет синтез ферментов,
сборка рибосом. Продолжительность - 4-5
часов.
• Экспоненциальная фаза – м-о размножаются с
мах скоростью (E. coli делится каждые 15-30
мин). Скорость роста зависит от состава среды,
физико-химических факторов среды (t, рН и
т.д.). Длительность - 5 - 12 часов.
19.
• По мере приближения к предельнойчисленности рост замедляется:
1. вследствие использования питательного
субстрата;
2. накапливаются продукты обмена до
токсичной концентрации;
3. увеличивается плотность популяции, идет
конкурентная борьба за источники питания;
4. начинают действовать механизмы
регуляции плотности популяции.
20.
• Стационарная фаза - устанавливаетсяравновесие между клеточным ростом и
делением бактерий, с одной стороны, и
процессом их отмирания, с другой стороны.
Спорообразующие бактерии переходят в фазу
споруляции. В этой фазе определяют выход
биомассы.
• Фаза отмирания – гибель клеток наступает
вследствие автолиза (под действием
собственных ферментов) и под действием орг.
кислот, вырабатываемых бактериями.
21. Параметры кривой роста периодической культуры
Выход биомассы (мг/мл):Х = Хmax – Х0,
где Х0 – исходная биомасса, Хmax –
максимальная масса бактерий.
Скорость размножения бактерий в
экспоненциальной фазе.
Продолжительность лаг-фазы.
22.
• Количество клеток бактерий определяют:путем прямого подсчета под микроскопом с
использованием счетных камер, метода
Виноградского-Брида,
используя метод серийных разведений с
последующим высевом суспензии на плотные
среды, считая, что одна колония – есть результат
развития одной клетки.
• Бактериальную массу определяют:
При помощи прямых методов: путем
взвешивания (сырую биомассу или сухие
отцентрифугированные клетки), по содержанию
общего белка, общего азота, общего углерода.
Косвенные методы: измерение оптической
плотности бактериальной суспензии, по
поглощению О2, по выделению СО2.
23. 3. Рост бактерий в непрерывной культуре
• Непрерывная культура – открытая система,стремящаяся к динамическому
равновесию.
• Непрерывное размножение культуры
обеспечивают коррекцией рН, подачей
свежей среды, отбором биомассы.
• Такой метод положен в основу
непрерывного культивирования в
хемостате.
24. Устройство хемостата
Хемостат состоит из сосуда-культиватора, вкоторый поступает с постоянной скоростью
питательный раствор.
Одновременно происходит постоянный отток
бактериальной суспензии, так что ее объем в
культиваторе не изменяется.
Культиватор снабжен мешалкой для
равномерного распределения свежей среды,
осуществляется аэрация.
Все это создает оптимальные условия для
развития культуры.
1 – регулятор
2 – поступление субстрата,
3 – отток (вымывание) смеси субстрата и
биомассы,
4 – культура внутри культиватора,
5 – мешалка
25.
При постоянном притоке свежей среды вкультиваторе плотность (количество) клеток (N)
сохраняется на постоянном уровне, т.к. скорость
деления клеток:
равна скорости их вымывания из культиватора:
где N - плотность клеток (или количество клеток);
μ – удельная скорость роста (час-1);
f – скорость поступления раствора (скорость протока) (литров/час);
V – объем сосуда (в литрах).
26.
Зависимость μ от концентрации субстрата Sустановлена Ж. Моно.
Уравнение Моно:
μ - удельная скорость роста;
S – концентрация субстрата в хемостате;
KS – константа сродства м-о к субстрату, численно равная такой
концентрации лимитирующего рост субстрата, при которой
скорость роста культуры равна ½ ее максимальной величины
(μmax/2).
27. Зависимость скорости роста от концентрации субстрата
28.
Культивирование в хемостате используется:• в промышленных условиях;
• для изучения физиологии м-о, кинетики их
роста, конкурентных взаимоотношений и
т.д.
29. Природный аналог хемостата – рубец жвачных
• В рубце постоянный приток питательныхвеществ, идет размножение м-о, которые
разлагают компоненты растительной пищи –
целлюлозу, лигнин и т.д.
• Это симбионтное питание (разложение
субстратов за счет микробных ферментов).
• Численность м-о постоянна - 109 -1010 кл/мл.
Излишек м-о выносится из рубца в кишечник, где
их биомасса переваривается (источник белка) –
симбиотрофное питание.
30.
• Продукты метаболизма (продуктыброжений) - жирные кислоты всасываются
слизистой рубца, служат энергетическим
субстратом для животных. Газы
выделяются.
• В рубце устанавливаются стационарные
концентрации субстрата, продуктов
метаболизма и биомассы м-о.






























 Биология
Биология